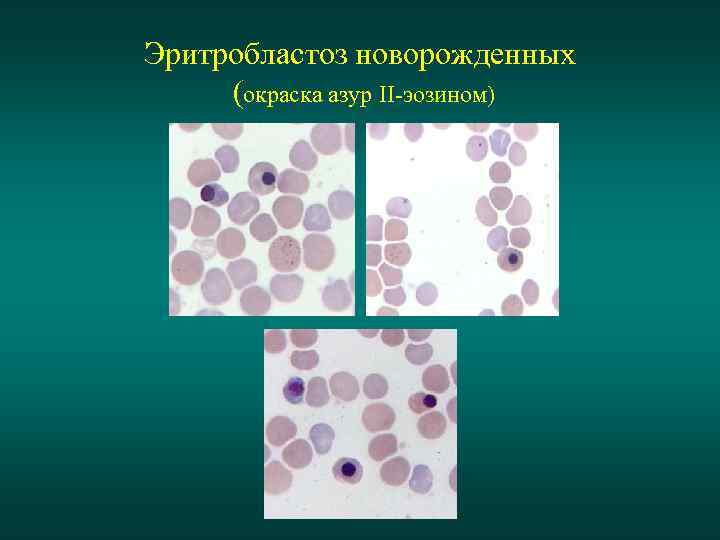
Эритробластоз новорожденных (окраска азур II-эозином)
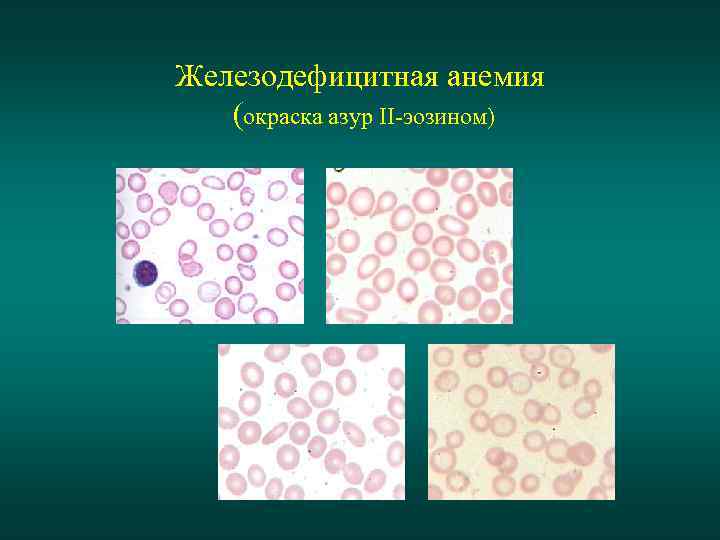
Железодефицитная анемия (окраска азур II-эозином)

Анемии.ppt
- Количество слайдов: 22

Кафедра патофизиологии Сиб. ГМУ Анемии

Классификация анемий Анемии вследствие кровопотери (постгеморрагические) ОПГА ХПГА Анемии вследствие нарушения кровообразования Дефицитные Анемии вследствие повышеного разрушения эритроцитов (гемолитические) Наследственные Приобретенные мембранопатии энзимопатии Гемоглобинопатии Снижение плацдарма кроветворения

Острая постгеморрагическая анемия Основные характеристики • • • Нормохромная Регенераторная Нормоцитарная Нормосидеремическая Нормобластическая Фазы компенсации ОПГА 1 – Сосудисто-рефлекторная фаза 2 – Гидремическая фаза 3 – Костно-мозговая фаза

Острая постгеморрагическая анемия сосудисто-рефлекторная и гидремическая фазы Картина крови: В сосудисто-рефлекторную фазу не изменяется (скрытая анемия) В гидремическую фазу идет равномерное снижение гемоглобина и эритроцитов, регистрируется нормохромная анемия, картина крови не изменяется

Острая постгеморрагическая анемия костно-мозговая фаза (окраска азур II-эозином и суправитальная окраска)

Хроническая постгеморрагическая анемия Основные характеристики • Гипохромная • Нормо-, гипорегенераторная • Микроцитарная • Гипосидеремическая • Нормобластическая Картина крови: • Анизоцитоз (умеренный или выраженный в зависимости от длительности и частоты кровопотери) • Пойкилоцитоз (умеренный) • Гипохромия • Единичные полихроматофилы

Хроническая постгеморрагическая анемия (окраска азур II-эозином)

Анемия Минковского-Шоффара микросфероцитоз Основные характеристики • Нормо-, относительно гиперхромная • Регенераторная • Микроцитарная • Гиперсидеремическая • Нормобластическая Картина крови: • Анизоцитоз (микроцитоз) • Сфероцитоз • Анизохромия (нормо- и гиперхромные эритроциты) • Полихроматофилы • Ретикулоцитоз

Анемия Минковского-Шоффара микросфероцитоз (окраска азур II-эозином)

Анемия Минковского-Шоффара микросфероцитоз (суправитальная окраска)

Гемолитическая анемия дефицит глюкозо-6 -фосфатдегидрогеназы Основные характеристики • Нормо-, относительно гиперхромная • Регенераторная • Микроцитарная • Гиперсидеремическая • Нормобластическая Картина крови: • Анизоцитоз • Анизохромия (нормо- и гиперхромные эритроциты) • Полихроматофилы • Ретикулоцитоз • Тельца Гейнца

Дефицит глюкозо-6 -фосфатдегидрогеназы (суправитальная окраска)

Серповидноклеточная анемия (окраска азур II-эозином и суправитальная окраска) Картина крови: • Пойкилоцитоз (серповидные эритроциты) • Полихроматофилы • Ретикулоцитоз

β-талассемия (окраска азур II-эозином) Картина крови: • Пойкилоцитоз (мишеневидные эритроциты) • Полихроматофилы • Ретикулоцитоз • Единичные нормобласты

Эритробластоз новорожденных Основные характеристики • • • Нормохромная Регенераторная Нормо-, макроцитарная Гиперсидеремическая Нормобластическая Картина крови: • Умеренный анизоцитоз • Нормобласты (всех степеней зрелости) • Полихроматофилы • Ретикулоцитоз • Базофильная зарнистость эритроцитов • Встречаются тельца Жолли
Эритробластоз новорожденных (окраска азур II-эозином)

Железодефицитная анемия Основные характеристики • Гипохромная • Нормо-, гипорегенераторная • Микроцитарная • Гипосидеремическая • Нормобластическая Картина крови: • Анизоцитоз (умеренный или выраженный, с преобладанием микроцитоза) • Пойкилоцитоз (умеренный, реже выраженный) • Гипохромия
Железодефицитная анемия (окраска азур II-эозином)

В 12 -дефицитная анемия Основные характеристики • • Гиперхромная Гипорегенераторная Макро-, мегалоцитарная Гиперсидеремическая • Мегалобластическая Картина крови: • Анизоцитоз (макро-, мегалоциты) • Пойкилоцитоз • Гиперхромные эритроциты • Эритроциты с тельцами Жолли и кольцами Кабо • Встречаются гиперсегментированные нейтрофилы

В 12 -дефицитная анемия (окраска азур II-эозином)

В 12 -дефицитная анемия костный мозг

Апластическая анемия костный мозг
Анемии.ppt